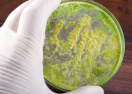
Медики предупредили об угрозе супербактерии, вызывающей бесплодие

Samsung представит три новых сервиса для платформы Smart TV на CES 2017
Ыamsung Electronics сообщила о готовности представить три новых сервиса для платформы Smart TV во время международной выставки CES 2017, которая будет проведена в период с 5 по 9 января в Лас-Вегасе.
Новые сервисы, в число которых входят «Спорт», «Музыка» и «TV Плюс», предложат пользователям персонализированный контент на основе их телевизионных предпочтений внутри Samsung Smart Hub.
«Одним из главных приоритетов деятельности Samsung является максимальное соответствие вкусам и потребностям пользователей, а также тому, что они хотят получить от своих умных устройств и электроники в целом, - говорит Вон Джин Ли (Won Jin Lee), исполнительный вице-президент подразделения Visual Display Business в Samsung Electronics. - С учетом этого мы продолжаем внедрять инновации в Smart TV для того, чтобы обеспечить пользователей именно тем качеством просмотра, которого они ждут от Samsung».
Samsung Smart TV «Спорт» сервис станет настоящей находкой для фанов. С ним поклонники спорта будут знать, когда играет их любимая команда, где можно посмотреть нужную трансляцию, а также какой сейчас счет, - и все это на одной навигационной странице. Вместо необходимости переключать десятки каналов в надежде отыскать какую-то важную игру, пользователи получат все ключевые данные благодаря кастомизированному и интуитивному пользовательскому интерфейсу «Спорт».
Samsung планирует увеличить объем доступного контента внутри сервиса «Спорт» путем объединения усилий с такими партнерами, как NBC Sports, UFC и другими.
Сервис под названием «Музыка» позволит владельцам устройств Smart TV с легкостью находить и идентифицировать те песни, которые звучат в прямом эфире или прямо внутри телевизионных программ. «Музыка» также будет рекомендовать те или иные треки внутри секции предварительного просмотра в пользовательском интерфейсе Smart Hub. Такое решение поможет пользователям знакомиться с новыми музыкальными композициями и наслаждаться любимыми песнями в любую секунду.
В данный момент сервис «Музыка» от Samsung предлагает контент из восьми музыкальных приложений-партнеров, представленных Spotify, iHeartRadio, Napster, Deezer, Sirius XM, Vevo, Melon и Bugs. Поначалу сервис будет доступен во Франции, Германии, Италии, Южной Корее, Испании, Великобритании и США.
Наконец, «TV Плюс» порадует пользователей каналами IP-телевидения. Последние будут направлены на предоставление премиум-контента при помощи решения под названием Smart Electronics Program Guide (EPG). Это значит, что пользователям Samsung больше не придется ждать специалистов по настройке кабельных сетей для того, чтобы окунуться в просмотр своих любимых телевизионных программ. Они смогут немедленно сделать это, просто включив нужный канал на «TV Плюс».
Для начала Samsung запустила «TV Плюс» в Юго-Восточной Азии. В данный момент он также доступен в США, а уже в апреле 2017 года ощутить все преимущества данного сервиса смогут и жители Европы. Предоставить премиальный T-VOD контент в США и Европе поможет сотрудничество Samsung с Fandango и Rakuten соответственно, а A-VOD контент в Германии - позволит объединение усилий с Funke.
CES Samsung UFC Германия Европа Италия США Франция